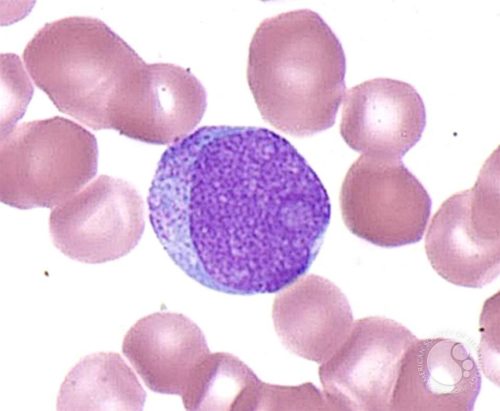

Миелоциты: классификация и норма
- нейтрофильные;
- эозинофильные;
- базофильные.
Нейтрофильные миелоциты содержат протоплазму розового оттенка. Также у первых клеток имеется крупная зернистость. Являются наиболее зрелым типом относительно двух других. Базофильные миелоциты содержат фиолетовую протоплазму, а эозинофильные розово-красную с крупными вкраплениями. Их количество в костном мозге определяется методом пункции. Нормы содержания клеток представлены в таблице.
| Тип клеток | Количество |
| Эозинофильные | 0,5-2% |
| Нейтрофильные | 5-10% |
| Базофильные | 0,2-1% |
Миелоциты, незрелые клетки крови, обычно не присутствуют в периферической крови здорового человека. Врачи отмечают, что их появление может свидетельствовать о различных патологиях, таких как острые лейкозы, анемии или инфекции. Нормальные значения миелоцитов в анализе крови должны быть равны нулю. Повышение их уровня может указывать на активное кроветворение в ответ на стрессовые состояния организма или на наличие серьезных заболеваний. Лечение, как правило, направлено на устранение первопричины, что может включать химиотерапию, радиотерапию или другие методы, в зависимости от диагноза. Важно, чтобы пациенты регулярно проходили обследования и следили за изменениями в анализах, так как ранняя диагностика может существенно повысить шансы на успешное лечение.

Врачи отмечают, что миелоциты, являющиеся незрелыми клетками крови, обычно отсутствуют в периферической крови здорового человека. Их присутствие может указывать на различные патологии, включая острые лейкозы и другие заболевания костного мозга. Нормальные значения миелоцитов в анализе крови составляют 0-1% от общего числа лейкоцитов. Повышение их уровня может быть связано с инфекциями, воспалительными процессами или гемобластозами. Важно провести комплексное обследование для выявления причины изменения. Лечение зависит от основного заболевания и может включать химиотерапию, иммунотерапию или поддерживающую терапию. Врачи подчеркивают, что ранняя диагностика и адекватное лечение играют ключевую роль в прогнозе для пациента.

Миелоциты в крови: причины, диагностика и лечение
Промиелоциты, миелоциты, метамиелоциты в крови должны отсутствовать у здорового человека. Их появление имеет ряд патологических причин. Могут возникать на фоне воспалительных процессов в организме — пневмония, туберкулез, пиелонефрит, инфекционные болезни ЛОР-органов. Ожоги и другие травмы, сопровождающиеся потерей крови и некрозом тканей, вызывают образование клеток данного типа в крови.
Выявление в анализе миелоцитов может сигнализировать о лейкозе и других онкологических заболеваниях. Возникает при ацидозе, после перенесенного инсульта и инфаркта, в состоянии комы и шока, при проведении лучевой и химиотерапии. Отклонение может быть обозначением отравления организма, дефицита железа и фолиевой кислоты, физической перегрузки. Прием некоторых медикаментов вызывает появление в крови данных клеток.
Миелоциты в крови у ребенка могут иметь другие причины, чем у взрослого. Возникают на фоне заболеваний желудочно-кишечного тракта, врожденного порока сердца, обезвоживании и интоксикации организма, ослаблении иммунитета, а также при повышенных физических нагрузках. Для новорожденных нормальным является показатель 0.5%. У беременных женщин незначительное повышение в крови миелоцитов допустимо. Предельное содержание — 3%.
Диагностика
К анализу крови на выявление содержания клеток потребуется специальная подготовка. Забор материала должен осуществляться натощак. Запрещено употребление алкоголя накануне исследования, жирной, жареной и соленой пищи, а также курение непосредственно перед анализом. Рентген или физиопроцедуры могут исказить результат. Для точности потребуется несколько анализов.
После лабораторного исследования необходима консультация терапевта. На основании данных, полученных в результате осмотра, а также после изучения анамнеза пациента, назначаются дополнительные диагностические меры. Лечение зависит от причины отклонения и возможно только после ее выявления. Важно!
Превышение миелоцитов на 10% и более угрожает жизни человека. Требуется немедленная госпитализация.
Миелоциты — это незрелые клетки, которые обычно не встречаются в периферической крови здорового человека. Их наличие может указывать на различные патологические состояния. Нормы в анализе крови предполагают отсутствие миелоцитов, однако их повышение может свидетельствовать о серьезных заболеваниях, таких как лейкоз, инфекционные процессы или анемия. В таких случаях важно провести дополнительные исследования для выяснения причины. Лечение зависит от основного заболевания: может включать химиотерапию, антибиотики или другие методы. Регулярные анализы крови помогают контролировать уровень миелоцитов и своевременно выявлять возможные отклонения.

Миелоциты — это незрелые клетки крови, которые обычно не встречаются в периферической крови здорового человека. Их наличие может указывать на различные патологии, включая острые и хронические заболевания крови. Нормальные показатели миелоцитов в анализе крови составляют 0%. Повышение их уровня может быть связано с острым миелоидным лейкозом, инфекциями, анемиями или другими состояниями, требующими активного кроветворения. Лечение зависит от основной причины повышения: может включать химиотерапию, трансплантацию костного мозга или другие методы. Важно регулярно проходить медицинские обследования и следить за состоянием здоровья, чтобы своевременно выявлять возможные отклонения.
Лечение и профилактика
Появление миелоцитов в крови не является самостоятельным заболеванием, поэтому тип лечения определяется причиной их появления в крови. Возможна медикаментозная терапия, хирургическое вмешательство, либо их комплекс. Отклонение, вызванное дефицитом железа или фолиевой кислоты, устраняется коррекцией рациона и употреблением специальных препаратов. При возникновении патологии на фоне приема некоторых медикаментов, необходима полная их отмена или замена аналогичными по действию препаратами. Правильно подобранная терапия приводит в норму показатели за 2-3 недели.
Профилактическими мерами являются здоровый образ жизни, сбалансированное питание, умеренные физические нагрузки. Не следует заниматься самолечением и бесконтрольно принимать лекарственные препараты. Необходимо исключить воздействие токсических и радиоактивных веществ.
Миелоциты обеспечивают полноценное созревание важных клеток в организме человека — гранулоцитов. Они необходимы для функционирования иммунитета человека и процесса кроветворения. В норме миелоциты должны содержаться только в костном мозге в виде эозинофильных, базофильных и нейтрофильных клеток. Появление этих составляющих в крови сигнализирует о гематологических отклонениях или развитии опасных патологий. Для назначения лечения необходимо выявление причины данного отклонения.
Вопрос-ответ
Что такое миелоциты и какую роль они играют в организме?
Миелоциты — это незрелые клетки, которые являются предшественниками нейтрофилов, одного из типов белых кровяных клеток. Они образуются в костном мозге и играют важную роль в иммунной системе, помогая организму бороться с инфекциями и воспалениями.
Какие причины могут привести к повышению уровня миелоцитов в крови?
Повышение уровня миелоцитов может быть связано с различными состояниями, такими как острые инфекции, воспалительные процессы, лейкозы или другие заболевания костного мозга. Также это может происходить в ответ на стрессовые ситуации для организма, такие как травмы или операции.
Как проводится лечение при повышении миелоцитов?
Лечение повышенного уровня миелоцитов зависит от основной причины, вызвавшей это состояние. В некоторых случаях может потребоваться лечение инфекций или воспалений, в других — более серьезные меры, такие как химиотерапия или другие методы, направленные на лечение заболеваний костного мозга. Важно обратиться к врачу для определения точной причины и назначения соответствующего лечения.
Советы
СОВЕТ №1
Регулярно проходите медицинские обследования, включая анализы крови. Это поможет своевременно выявить отклонения в уровне миелоцитов и других клеток крови, что может быть признаком различных заболеваний.
СОВЕТ №2
Обратите внимание на свое питание. Употребление продуктов, богатых витаминами и минералами, такими как фрукты, овощи и белковые продукты, может поддерживать здоровье крови и нормализовать уровень миелоцитов.
СОВЕТ №3
Если у вас обнаружены повышенные уровни миелоцитов, не откладывайте визит к врачу. Консультация специалиста поможет определить причины изменений и назначить соответствующее лечение.
СОВЕТ №4
Избегайте стрессов и физических перегрузок. Психоэмоциональное состояние и уровень физической активности могут влиять на состав крови, поэтому старайтесь поддерживать баланс между работой и отдыхом.


